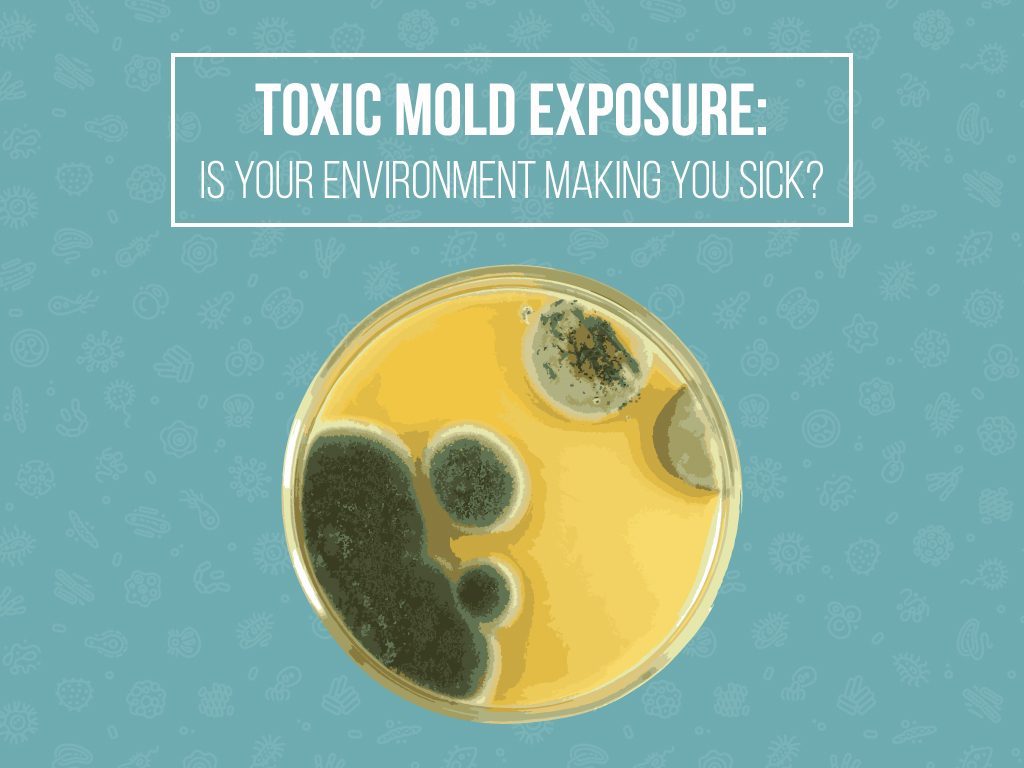

Dr. Jay Davidson on “Toxic Mold and Lyme Disease”
April 1, 2018
Dr. Jay Davidson wrote a blog article called “What’s the Connection Between Toxic Mold and Lyme Disease?”
From the article:
One of the most significant issues that Lyme-disease sufferers face is that they struggle to release toxins from the body. Lyme disease patients cannot naturally get rid of biotoxins even when removed from the source of the exposure.
When the immune system is struggling to work at full capacity, a common problem for Lyme sufferers, you struggle more with exposure to illness. Because the immune system is already struggling with Lyme disease, you might experience the results of mold sickness more strongly than someone with a mold allergy.
Additionally, people with Lyme disease can develop chemical and mold sensitivities after beginning treatment. Many sufferers experience intolerances during treatment that can prompt additional allergic reactions. Though you may have always had an underlying mold allergy, you may not have experienced severe symptoms before acquiring Lyme. This is because Lyme disease brings out the allergens more aggressively in response to the toxins in your body.
Links on this page are in orange (no underlining).